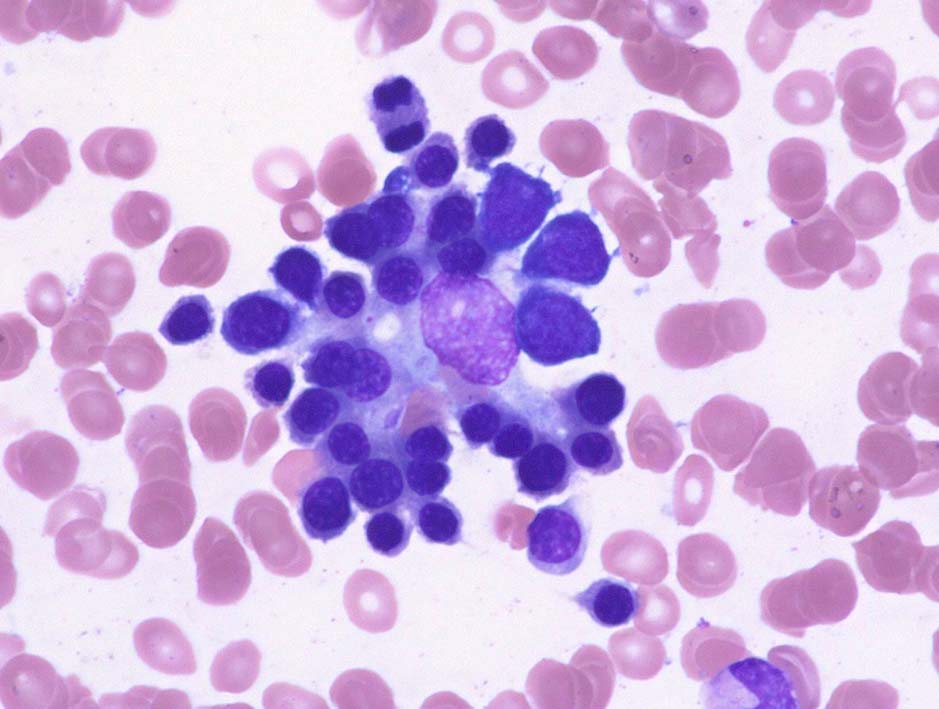
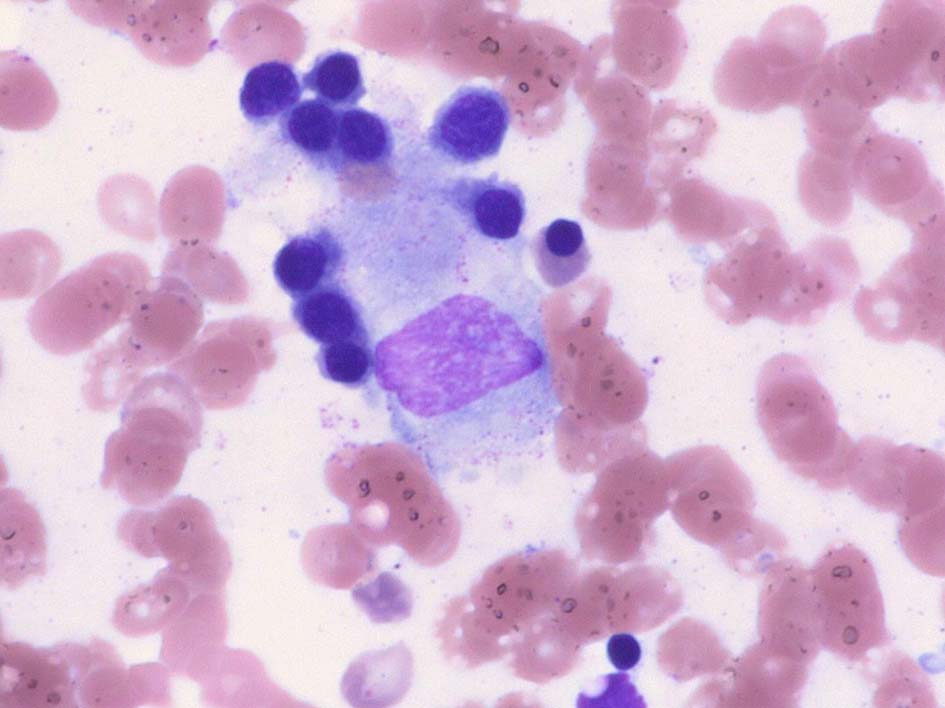

Wikipathologica-KDP
赤血球系造血細胞 erythroid cells†
赤血球系の細胞は赤芽球系前駆細胞→前赤芽球→赤芽球→網赤血球→赤血球へと分化*1する
赤血球系の細胞は骨髄で3-4日増殖し(分裂能を有するのは前赤芽球から多染性赤芽球まで), 成熟のため1-2日骨髄にとどまり,網赤血球の形で末梢血に放出される。網赤血球は正常では赤血球の1%ほど (基準値 0.2- 2.6%)[ ‰では2-26]
赤芽球系前駆細胞†
骨髄球系共通前駆細胞から前赤芽球までは特異的なマーカがなく形態的にも芽球様を示し他の系統の前駆細胞と区別することは困難であった.コロニーアッセイ法は, この段階の前駆細胞の種類および数を判断することができた。
コロニーアッセイ法により赤芽球性前駆細胞には2種類あることがわかった
- 1.BFU-E: burst-forming-unit-erythroid
造血幹細胞より派生する骨髄系の最も幼若な前駆細胞であるCFU-mixから分化成熟してできる。赤芽球系の最も幼若な細胞.骨髄細胞を粘調な培地でエリスロポイエチン(EPO)大量存在下に培養して約14日に観察される.
- 2.CFU-E: colony-forming-unit-erythroid
分化がある程度進んだ前駆細胞で,エリスロポイエチン(EPO)存在下で7日目に小型の赤芽球コロニーを形成する. BFU-EからCFU-Eへの分化はmulti-CSFに対する依存性がEPO依存性に変換していきCFU-EはEPOの作用で赤芽球に分化する.
赤芽球系前駆細胞同定 up to date†
現在は, multi-color FACSと新規抗体により, 赤芽球系前駆細胞の同定がおこなわれるようになった.*2
森らは, ヒト造血システムにおいて, CD71とCD105を追加したmulti-color FACSにより骨髄中に赤芽球系統特異的前駆細胞(erythroid progenitor;EP*3)を単離し, その分化経路/分化機構について検討している.
- CD71 transferrin receptor;休止期の細胞には発現せず, 種々の活性化細胞に発現する. Feを大量に代謝する必要のある早期の赤芽球系細胞に発現する表面マーカとして知られている.(赤芽球系のみではないことに注意)
- CD105 endoglin; TGF-βのⅢ型受容体複合体構成要素の一つでCD71と同じく分化初期の赤芽球系細胞(CD34陽性)に発現する表面マーカ
- CD71はMEP(Megakaryocyte/erythrocyte progenitor)より上流のCMP(common myeloid progenitor)レベルから発現している(31.5±11.1%). MEPでは大部分が陽性であった(82.3±6.4%)
- CD105の陽性が確認されたのは CD71陽性MEPのみであった.
- CD71陰性CMPと比較してCD71+ CMPは巨核球・赤芽球系へ偏った分化能を示した.
- CD71+, CD105- MEPはMgkへの分化能をわずかに残しながら主としてBFU-Eを形成したのに対して, CD71+, CD105+ MEPはCFU-E主体にerythroid-colonyのみを形成してMgkポテンシャルを失っている.
- 巨核球分化に適した無血清液体培養下でもCD71+, CD105+ MEPからはGlycophorin-A+のみの赤芽球が産生されCD41+のMgk産生能は確認できなかった.
- 以上の結果よりCD71+,CD105- MEPがErythroid-biased MEP(E-MEP)でありCD71+, CD105+ MEPがヒトEPとして同定された
- 従来のMEP分画¬e;は不均一な細胞集団であり, bi-potentなMEPは Lin- CD105-, CD34+ CD38+ IL-3Rα- CD45RA-中のみに存在することになる.
ヒトEP(erythroid-progenitor)=CD71+ CD105+ MEPの分化経路
- CD71- CMPは短期液体培養系において培養3日目にCD71+ CMPのほか, 顆粒球・単球系前駆細胞(granulocyte/macrophage progenitor, GMP)やMEPへの分化が確認される.
- CD71+ CMPからはCD105陽性EP分画を含むMEPへの限定的分化能が示され, GMPは出現しない.
- CD71+ CMPはCD71- CMPからMEPへ向かう中間段階に存在すると考えられた.
- CD105- MEPからCD105+ MEP(EP)への一方向的分化が確認されヒトEPがCD105-MEPの下流に存在することが明らかになった.
- CD71- CD105- MEPとCD71+ CD105- MEP(E-MEP)には双方向性分化が観察されCD71- CMPからCD71+ CMPを経由せず直接にCD71-MEPに向かうマイナーな経路の存在も示唆された.
前赤芽球 proerythroblasts†
- 形態学的に赤血球系と判断できるもっとも未熟な細胞で4回の連続する細胞分裂を経てヘモグロビン化され無核赤血球となる
- Proerythroblast(プロエリスロブラスト)またはrubriblast(ルブリブラスト, rubri-->ruby赤)と呼ぶ。
- 直径20μmほど.赤芽球系細胞では最大. 類円形の核を細胞中心にもつ.クロマチンは繊細顆粒状でアズキ色の点描のように見える.核には青みの強い核小体を2-3個もつ.
- 細胞質はpolysome(RNAに富むribosomeが数個ずつ集まり集塊を作る)が多く全面紺青色を呈する. ただし前駆細胞より分化したばかりではpolysomeを増やす段階でまだ細胞質の青色調は濃くなっていないことに注意.
- 細胞質辺縁には,瘤状のbleb(blisterともよぶ)を形成することがある。これがあればこの幼若細胞が前赤芽球の可能性がある.
- proerythroblastsの陽性マーカ(FCM)は, CD36, CD38, CD45, CD71, CD117, glycophorin (CD235a; dim), HLA-DR (moderate) でCD34の発現もありうる.*4
赤芽球 erythroblasts†
赤芽球の形態, 特徴--> &ref(): File not found: "erythroblasts.pdf" at page "Erythroid cells"; smearの形態.
- 赤血球系の分化が進むにつれてヘモグロビン量が増加するために細胞質が赤く染まるようになる。
- hemoglobin合成は前赤芽球段階から開始される. 塩基性赤芽球, 多染性赤芽球へ分化するにつれてその合成が急速に促進され, 同時に分裂能も消失する.*5--分裂能を有するのは前赤芽球から多染性赤芽球まで.
- hemoglobin合成増加による色調変化のため, 前赤芽球以降の赤血球細胞を形態学的に好塩基性赤芽球, 多染性赤芽球, 正染性赤芽球の3つに分類するが, この段階わけはあまり重要ではない(柴田先生)
★赤芽球:芽球とは本来,細胞形態的に分類同定しうる最も幼弱な段階の細胞をいうが, 赤芽球は有核赤血球のことであり, 同じ意味のものではない。erythropoiesisで本来の芽球にあたるものはproerythroblast(前赤芽球)です。
- EPOに支持されたCFU-Eは3-4回分裂し前赤芽球→赤芽球への分化がすすみHb蓄積, 特異的膜赤血球構造形成, 好気性から嫌気性代謝への変化が見られ脱核する
- 核は赤芽球細胞質の一方に押しやられ最後は細胞膜と細胞質の一部をともない分離放出される. 放出された核は中心マクロファージが取り込み分解処理をする。
網赤血球 reticulocytes†
網赤血球は成熟赤血球より大きく8-10μmでGiemsaやwright染色ではやや青みがかった多染性の赤血球として観察できる. 生体外にとりだした網赤血球の試験管内半生存時間は4.8±1.9時間といわれる.
生体外の生きたままの赤血球を染色する超生体染色によりRNAを含むミクロソームが網状顆粒質(substantia granulofilamentosa)として細胞質内に染色, 同定される.
網状赤血球の増減は骨髄造血状態を評価するよい指標でありAA, 抗白血病薬投与後, 重症感染症極期など造血低下の時は減少し, 鉄欠乏性貧血, 出血, 溶血性貧血などでは増加する.
鉄欠乏性貧血や巨赤芽球性貧血治療時にはHbの増加に先行して一過性に増加する. 治療効果ありの手がかりになる.
正常値は 正常成人で 5-10‰, 新生児生後1週間以内では2-56‰(平均21‰)
成人では1日に2000億個の赤血球が骨髄で産生され全身に絶え間なく酸素を供給している.
Erythroblastic island 赤芽球血島†
AML-M7の骨髄生検タッチ標本にみられたErythroblastic island.
赤芽球血島:Erythroblastic island
- 赤芽球が中心マクロファージ(nurse cell)の周囲に接着した形で認められる構造. 中心マクロファージは非常に繊細な細胞質突起で赤芽球を包んでいる. 赤芽球には幼若細胞から成熟した赤芽球まで種々の分化段階の細胞が認められる.骨髄内に赤芽球島とよばれる小集団を形成している。
- 中心マクロファージと赤芽球はカルシウム依存性接着因子で接着している. HE, Naphtol-ASD-CAE染色の骨髄組織では同定が困難で赤芽球のみしか確認できないことがほとんど.
- 中心マクロファージはVCAM-1を発現,赤芽球に発現するVLA-4のα4-integrinと接着する.
- マクロファージから産生されるIL-1,IFN-γ,TNF-α,GM-CSF,G-CSFは骨髄造血を亢進させる一方で赤血球造血には抑制的に作用する.
- 赤芽球血島は骨梁周囲にはほとんど認められず, 骨梁周囲に多い顆粒球系造血巣と対照的である.
- 赤芽球血島が骨梁周囲に存在する所見は異常. MDSなどに認められる abnormal localizaion of immature precursor(ALIP)に相当する.
- 赤芽球島は静脈洞に近接して存在することが多く, 正常骨髄の赤芽球島は平均22.5個の赤芽球からできている。
- 前赤芽球proerythroblastは単独, 孤在性に存在する傾向が強く, 分化がすすんだ赤芽球で構成される血島ほど大きくなる.
- 脱血刺激では, 血中エリスロポエチン濃度が高いほど赤芽球血島が集合し赤芽球系造血巣は拡大する.
- 溶血性貧血では骨髄に代償性赤血球系造血亢進がおこり赤芽球数が増加し赤芽球島は大きくなる。
- 再生不良性貧血, 骨髄線維症では赤芽球島の赤芽球数は減少している。
- 骨髄には平均赤血球産生の約7倍の赤血球生産予備能力があるといわれている
赤血球造血-赤芽球の分化と増殖†
第13回骨髄病理研究会「赤芽球」東北大学大学院医学系研究科 張替 秀郎先生の講演より
赤血球造血 erythropoiesisの重要な3つの因子
1. 赤血球造血の内的因子---GATA1, GATA2転写因子とその複合体が主役
2. 赤血球造血の外的因子---erythropoietinが主役
3. globin量を調節してヘム・グロビンが正確に同量の四量体を形成する---Hemeが主役
以上の3つの因子が赤血球造血に重要な役割を果たしている。
赤血球造血の内的因子†
GATA転写因子群 GATA transcription factors
GATA転写因子は,GATA-1からGATA-6の6種類が報告されている.
- 特徴として,すべてのGATA転写因子が転写の制御領域であるpromoterまたは enchancerのGATA塩基配列を認識して結合,下流にある必要な遺伝子の転写をONにする。
- しかし,GATA転写因子により機能している細胞系列, 組織系列が異なっている.
GATA1(Xp11.23): 赤血球系, 巨核球, 肥満細胞, 好酸球に発現.
GATA2(3q21.3): 造血幹細胞, 造血前駆細胞(巨核球, 肥満細胞など)
GATA3: Tリンパ球
(GATA1-3は造血系GATA転写因子;hematopoietic GATA transcription factorsとも呼ばれる)
GATA4,GATA5,GATA6: 心臓など内胚葉由来細胞 (GATA3も)
- GATA-2は造血幹細胞に発現し,幹細胞の維持, 増殖に重要な役割をはたす*6
- GATA-1は一部GATA-2と発現が重複するが, GATA-2に次いで発現し赤芽球, 巨核球, 好酸球, 肥満細胞の分化に関与する.
- GATA-3はT細胞分化に重要*7である.
- 赤血球系では分化に伴ってGATA2とGATA1の発現量が変化し、様々な赤血球系の遺伝子発現を制御している。
GATA switch
造血前駆細胞においてGATA-2は自分自身を活性化するとともにGATA-1を活性化する. 一方GATA-1はGATA-2の発現を抑制し赤血球分化の過程においてGATA-2からGATA-1への発現移行が行われる. *8*9*10
GATA1の機能と複合体†
GATA1は赤血球造血に必須の転写因子.
transferrin receptor, ferritin, mitoferrin, すべてのヘム合成系遺伝子, グロビン,赤血球膜成分,エリスロポイエチン受容体, etc すべての赤血球関連遺伝子発現がGATA1の制御下にある.
GATA1は赤血球が赤血球らしくなるため遺伝子の転写をになっているマスター遺伝子である.
GATA転写因子は単独の転写因子のみで赤血球の遺伝子を転写できるわけではなくGATA転写因子が中心となり複合体をつくりこの複合体が赤血球の特異的遺伝子の転写をになっている。
複合体中のETO2, LMO2の働き*11
ETO-2; ETO familyに属する核タンパク質*12
- 転写抑制作用をもつ(class I HDAC);ヒトex vivo赤芽球でETO-2をknock downするとHbβ, αの発現が上がる.(分化がすすむ)
- 赤芽球, 巨核球分化および造血幹細胞の機能に関連している。
LMO-2*13
- knock downによりETO2と逆にHbβ, αの発現が低下する.
- タンパクを減少させると, GATA1やSCL/TAL1の量は変わらないがLMO2にくっつく量が減る.
GATA転写因子複合体をくっつけているタンパク質
複合体はGATA1を中心に形成されているが, LMO2が複合体をのりづけしたり, 転写刺激が必要ない場合はETO2が入ってきて転写を抑制するように働く*11.
赤血球造血の外的因子 Erythropoietin†
Erythropoietin; 外からの赤血球造血のマスター因子.
Epoは糖鎖を豊富に含む34kDaの糖タンパク質で, 赤芽球系前駆細胞やヘモグロビン合成をはじめる前の赤芽球に作用して赤血球造血を亢進させる.*14
神経系細胞において細胞保護作用が認められている.*14
Renal EPO-producing cells(REP細胞)
今までは腎臓のどの細胞がEPOをつくるかわかってなかったがトランスジェニックマウスの実験系で
間質細胞の線維芽細胞様細胞が産生していることが報告された. *15
- Renal EPO-producing cells(REP細胞); CD73+, PDGFRβ+ = peritubular fibroblasts(腎皮質間質線維芽細胞[様]細胞)
- glycolysis genesのneural isoform, Glut3, Aldoc and Pfkfb3遺伝子などを発現している.
なぜ酸素分圧が下がると(貧血), EPOが産生されるのか
健康な成人骨髄中酸素濃度は 7%で, 貧血になると1%まで低下することが報告されている. 低酸素により活性化される転写因子HIF(hypoxia-induced factor)により腎臓でのエリスロポエチン産生が増加し, 赤芽球系後期前駆細胞(CFU-E)の増殖分化が促進される.-->HIF
赤血球 erythrocytes†
赤血球は体細胞にある核や細胞小器官を備えていません.線維性蛋白で裏打ちされた脂質皮膜でヘモグロビンなどを含む液体を包んだ袋状の細胞です.
直径約8μmで両面中央のくぼんだ円盤形をしています。この形は球形のような自然な形ではなく, 形態を保つために赤血球はエネルギーを必要とします。
赤血球膜の電顕写真
脂質二重膜直下の白矢印で示した低電子密度の薄い層はスペクトリン線維などから形成されている赤血球膜骨格の部分
赤血球膜の構造†
赤血球膜骨格
赤血球膜はスペクトリンspectrinと呼ばれる線維蛋白のフィラメントが六角形の網目状構造を形成し立体的に円盤形の網目かごをつくり, その外側に脂質の皮膜をかぶせて内容の高濃度ヘモグロビンがもれないようにしている。
六角形の網目の骨格をなすスペクトリンは四量体でフィラメントを作っている。フィラメントの中央にはアンキリンankyrinと呼ばれる球状蛋白が, 両端にはアクチンや4.1蛋白というアンカー蛋白質が付着している。
スペクトリンは線維状蛋白でα鎖とβ鎖が反対方向にゆるくコイル状に寄り添い側面で非共有結合してヘテロ二量体をつくる。二量体の頭部ではα鎖とβ鎖が結合して四量体となり網目状膜骨格の基本単位になる。αβ鎖はともに106個のアミノ酸からできた三つ折れの逆平行αへリックスを基本単位とする繰り返し構造が連続しておりスペクトリンの屈伸性を保持している。
脂質皮膜
脂質皮膜成分はリン脂質, 遊離コレステロールなどで疎水性部分と親水性の部分の流動性二重膜構造をとる。膜には内在性蛋白が膜を貫通したり、埋め込まれたり、共有結合をして存在する。内在性蛋白にはバンド3, グリコホリンglycophorins, ATPaseなどがある。